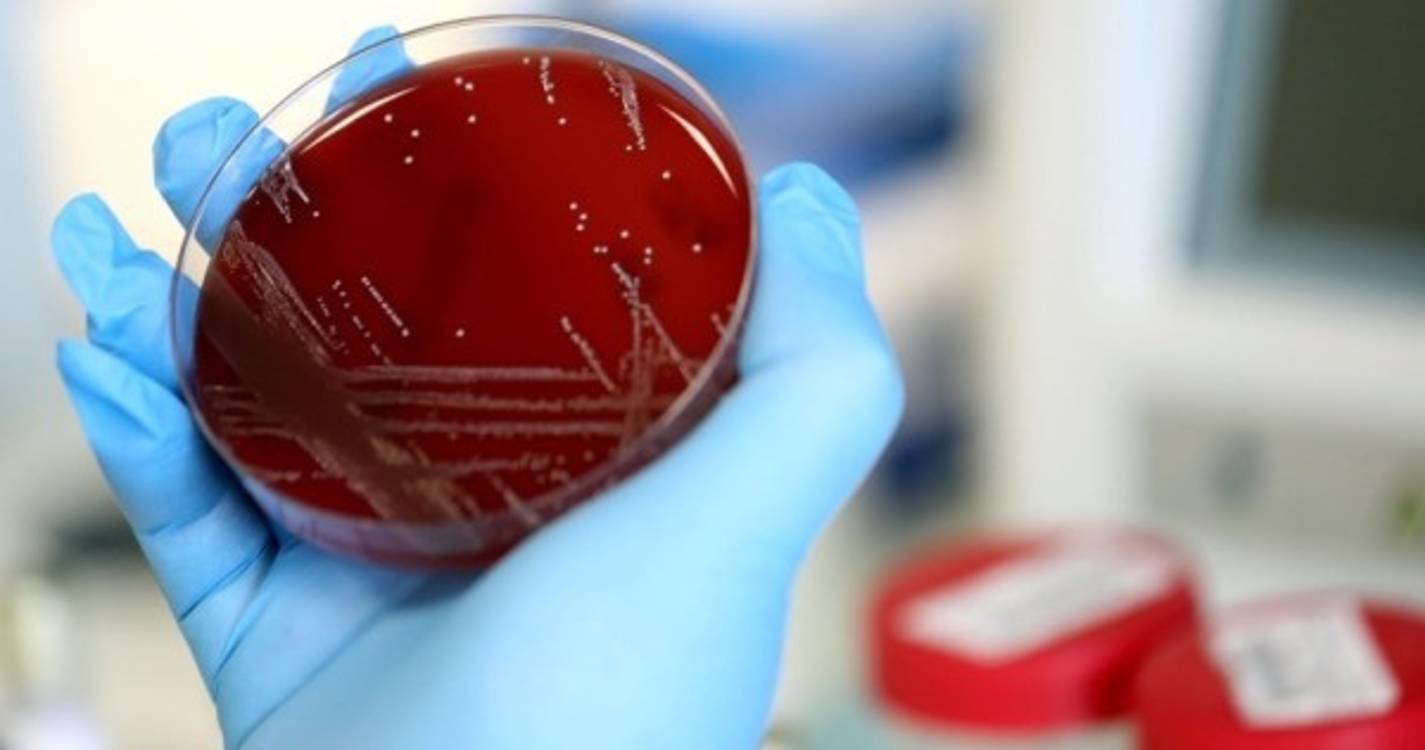

Mais de 2,2 milhões de mortos no mundo devido à covid-19
Ao todo, o mundo já contabiliza 2.269.346 de mortos e mais de 104.350.880 infetados, desde o início da pandemia, segundo o balanço da AFP.
Só nas últimas 24 oras, somaram-se mais 15.331 mortos e 501.061 casos de covid-19 à volta do globo.
A estes valores acrescenta-se ainda o facto de que pelo menos 63.406.500 de pessoas já foram consideradas curadas.
No top de países mais afetados, em termos de mortes, continuam a estar os EUA, com 3.540 óbitos, seguido do México (1.707) e do Reino Unido (1.322).
Também em termos de casos, os EUA surgem como os líderes, com 246.557.354 infeções confirmadas, segundo a contagem da universidade Johns Hopkins.
Depois dos Estados Unidos, os países mais afetados são o Brasil, com 227.563 mortes e 9.339.420 casos, o México (com 161.240 mortos e 1.886.245 casos), a Índia (com 154.703 mortos e 10.790.183 infetados) e o Reino Unido (109.335 mortes em 3.871.825 casos).